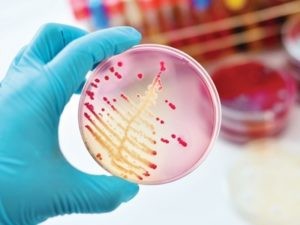

В последние годы можно было встретить довольно противоречивые заголовки новостей о домашних кошках.
Согласно первым, питомцы способны свести человека с ума, и речь в данном случае не шла о радости от просмотра очередного видеоролика.
Специалисты обвиняли паразита вида Toxoplasma gondii в развитии серьёзных психических заболеваний, например, шизофрении. Переносчиком T. gondii как раз являются кошки. Впрочем, в других статьях утверждалось обратное.
Как поясняют «Вести.Наука», Toxoplasma gondii действительно вызывает инфекционное заболевание токсоплазмоз. И, предположительно, около 65% людей на планете являются носителями токсоплазмы, хотя данные сильно отличаются для разных стран.
Токсоплазмоз в большинстве случаев протекает бессимптомно или может проявляться как заражение обычным вирусом гриппа. Однако для людей с подавленным иммунитетом и для растущего во чреве матери плода болезнь может дать тяжёлые осложнения вплоть до летального исхода.
Антибиотики могут вылечить инфекцию, однако не способны полностью «изгнать» паразита из организма.
Учёные уже давно выдвинули гипотезу, согласно которой паразиты T. gondii играют определённую роль в развитии психических заболеваний, в том числе шизофрении. И ранее специалисты провели более ста работ, в которых действительно была показана подобная корреляция.
Но есть одно «но»: ни одно исследование не продемонстрировало, что паразит в самом деле вызывает именно этот недуг.
Собственно, в связи с этим возникает вполне закономерный вопрос: так как же дело обстоит на самом деле?
Сначала объясним, как злосчастный T. gondii может оказаться в организме человека.
Усатые и хвостатые звёзды Интернета «подхватывают» незваного гостя и токсоплазмоз, поедания инфицированных грызунов, птиц или других животных.
Согласно некоторым данным, только в США примерно 40% кошек являются инфицированными. Причём у них может не проявляться никаких симптомов, хотя в некоторых случаях развивается желтуха или слепота.
В первые несколько недель после заражения кошка может ежедневно выделять в свой лоток миллионы выносливых ооцист.
Некоторые люди могут заразиться токсоплазмозом при прямом контакте с домашними питомцами и кошачьими фекалиями. Большинство же заражается, когда ооцисты, оставленные кошками, попадают в почву и воду, где они могут выживать в течение года и даже дольше.
Иными словами, в организм людей токсоплазмы могут попасть через контакт с кошачьими фекалиями, вместе с плохо приготовленным мясом или загрязнённой водой.
Паразит не даёт о себе знать, и после заражения люди не начинают чувствовать себя плохо. Но он может образовывать кисты в мозгу, где может находиться до конца жизни человека.
Почему некоторые учёные всерьёз считают, что токсоплазмоз может вызывать психическое заболевание?
Большая часть доказательств тому была получена благодаря исследованиям на грызунах: после заражения T. gondii у животных наблюдалось странное поведение. Например, они теряли всякий страх, учуяв запах кошачьей мочи (обычно животные замирают от страха или прячутся). Более того, в некоторых случаях грызуны упрямо шли навстречу своему врагу.
Специалисты считают, что T. gondii изменяет функции мозга, формируя кисты в областях, ответственных за возникновение страха и принятие решений.
Кроме того, кисты также могут влиять на поведение, повышая уровни дофамина – нейротрансмиттера, участвующего в вознаграждении и принятии риска.
Кроме того, появляется всё больше данных, свидетельствующих о том, что инфекция T. gondii способна изменить личность человека и увеличить вероятность развития у него шизофрении и других психических заболеваний.
Если даже не брать в расчёт непосредственное заражение мозга (и образование кист), хроническая инфекция T. gondii может привести к воспалению, которое, как предполагалось ранее, также связано всё с теми же с психическими расстройствами вроде шизофрении, а также с аутизмом и болезнью Альцгеймера.
Впрочем, если с животными всё более или менее понятно, то с людьми намного сложнее, пишет издание Sciencemag.
Несмотря на убедительность гипотезы о том, что токсоплазмоз может вызывать психическое заболевание, её чрезвычайно трудно проверить на людях, говорит генетик из Университета Дьюка Карен Сагден (Karen Sugden).
В 2016 году Сагден обнаружила, что 200 новозеландцев, инфицированных T. gondii, не имели значительно более высоких шансов заполучить шизофрению или любое другое психическое расстройство.
Но, по её мнению, это исследование не доказывает, что паразит не связан с психическим недугом. Шизофрения обычно не появляется до позднего подросткового или 20-летнего возраста.
Чтобы выяснить наверняка, вызывает ли токсоплазмоз шизофрению или нет, нужно знать, подвергались ли пациенты воздействию T. gondii, будучи детьми или подростками, то есть до того, как у них развилось психическое заболевание, объясняет учёный.
Между тем в её исследовании проверялись люди в возрасте 38 лет, и поэтому трудно сказать, что появилось раньше: шизофрения или паразит.
Многие корреляционные исследования, включая указанную работу Сагден, не располагают нужной информацией.
Кроме того, в исследовании Сагден, как и в других работах, использовалась небольшая выборка. Шизофрения – довольно редкое заболевание, обычно встречающееся примерно у одного процента населения.
А чтобы получить надёжные статистические результаты, исследователям необходимо изучать десятки или даже сотни тысяч людей в течение длительных периодов времени, периодически тестируя их на T. gondii и психические заболевания, говорит Сагден.
Что интересно, в январе 2019 года учёные опубликовали работу, посвящённую анализу более чем 80 тысяч датских доноров крови. Число диагнозов шизофрении было довольно небольшим – 151 человек.
Согласно исследованию, у людей, которые подвергались воздействию T. gondii, на 47% увеличивались шансы заполучить психическое расстройство.
Когда исследователи сузили свой анализ до 28 человек, у которых впервые была диагностирована шизофрения после положительного тестирования на воздействие T. gondii, они обнаружили, что у этих людей было в 2,5 раза больше шансов заполучить болезнь после такого воздействия.
Такие данные совпадают с результатами других крупных корреляционных исследований, в которых также обнаружилось примерно 2,5-кратное увеличение вероятности появления шизофрении у инфицированных людей, говорит вирусолог Роберт Йолкен (Robert Yolken) из Медицинской школы при Университете Джонса Хопкинса (он был одним из авторов датского исследования).
Поскольку общая частота диагностики шизофрении встречается редко, инфекция незначительно увеличивает шансы появления недуга: от одного к 100 до двух-трёх к 100.
Как предполагают Йолкен и его коллеги, T. gondii сам по себе не может вызывать психическое заболевание, однако он способен взаимодействовать с генетическими вариантами, которые делают некоторых людей более восприимчивыми к развитию недуга. Если это так, то T. gondii можно добавить в список факторов среды обитания, которые ненамного увеличивают риск появления шизофрении.
По мнению специалистов, даже если человек будет являться носителем латентной инфекции T. gondii, то шансы заполучить шизофрению как следствие токсоплазмоза малы (так показывают современные работы).
Пока специалисты не спешат говорить о точных цифрах, однако они считают, что инфекция находится в одном ряду с другими факторами риска появления заболевания, о которых человек, скорее всего, мало беспокоится (например, проживание в городе).
Что же касается советов по предотвращению заражения токсоплазмозом, то здесь всё довольно банально. Нужно содержать кошек в помещении, где они не могут охотиться на инфицированных животных, ежедневно утилизировать фекалии питомцев, правильно готовить пищу и соблюдать другие рекомендации.
В ходе наблюдений ученые пытались выяснить, как присутствующие в кишечнике бактерии влияют на настроение подопытных. С помощью МРТ и прочего оборудования специалисты фиксировали реакцию мозга на демонстрируемые картинки. Предварительно ученые разделили на две группы людей, психическое состояние которых, по их предположениям, могло зависеть от бактерий: в организмах первых преобладали бактерии рода бактероидов, у вторых было больше бактерий-превотелл.
Когда на экране появлялись изображения с ярким эмоциональным окрасом, мозг участников второй группы начинал работать интенсивнее. Среди них также было отмечено больше людей с депрессивными состояниями, беспокойствами и прочими негативными эмоциями. Окончательные выводы еще не сделаны, но ученые считают, что настроение людей, как и приматов, зависит от кишечных бактерий.
Токсоплазма
Паразитический протист Toxoplasma gondii, как правило, обитает в организмах представителей семейства кошачьих, но это вовсе не значит, что человеку нечего бояться. По официальным данным, половина населения всей планеты инфицирована токсоплазмозом — заболеванием, которое вызывают эти паразиты.
В большинстве случаев токсоплазмоз протекает бессимптомно. Организм излечивается от него самостоятельно, без медикаментозного вмешательства. Однако для тех, у кого наблюдается иммуннодефицит, это заболевание может быть опасно.
Ученые выяснили, что паразит Toxoplasma gondii оказывает влияние на поведение грызунов, заставляя их становиться бесстрашными. Подопытные теряли чувство опасности и совершали рискованные действия, например, едва ли не сами бежали в лапы к котам. Специалисты уверены, что таким образом токсоплазма влияет и на человека.
Неглерия Фоулера
На втором этапе заболевания могут проявиться рассеянность внимания, потеря равновесия, головокружения и даже галлюцинации. Заканчивается все кровоизлияниями и некрозом в сером и белом веществе мозга. В итоге у человека развивается амебный менингоэнцефалит, который, как правило, приводит к смерти.
С момента открытия простейшего Naegleria fowleri (1970 год) зарегистрировано несколько сотен случаев заражения им и лишь один случай выздоровления. В 2012 году в Иране от амебного менингоэнцефалита удалось излечить 5-месячного младенца. И хотя препараты для борьбы с бактерией существуют, помогают они далеко не всегда.
Малярия
Малярия – опасное инфекционное заболевание, передаваемое человеку при укусе комара рода Anopheles. Вызывается малярия паразитическими протистами рода Plasmodium, которые имеют интересный жизненный цикл. Большую часть своей жизни паразиты Plasmodium falciparum и Plasmodium vivax проводят в организме людей, оставшуюся — у комаров. Поэтому для распространения заболевания самка комара сначала кусает зараженного человека и только потом — здорового, таким образом передавая ему возбудитель.
Но интересно даже не это, а то, как паразит Plasmodium влияет на разум зараженного человека. Попадая в организм, он заставляет человека поглощать как можно больше глюкозы, ведь именно от нее в большей степени зависят возбудители болезни. Даже на этапе пребывания в организме комаров малярия вызывает у них желание получить глюкозу и делает более прожорливыми. Комаров тянет туда, где наиболее сильный запах нектара, а когда приходит время — им начинает хотеться человеческой крови, в которой также содержится это вещество.
Малярийные паразиты довольно быстро поглощают глюкозу и гормоны из крови, поэтому у зараженных людей часто наблюдается анемия, дефицит витаминов и снижение уровня сахара в крови. Все это приводит к тому, что больного начинает тянуть на сладкое, причем касается это как людей, так и комаров.
Вирус ATCV-1
Ученые уже выяснили, что вирус ATCV-1, который ранее считался исключительно альгофагом (организм, уничтожающий водоросли), также оказывает значительное влияние на поведение мышей, вызывая у них когнитивные нарушения. Однако, как оказалось, данный паразит опасен и для человека, и действует на его мозг аналогичным образом.
Бешенство
Когда речь заходит о заболеваниях, влияющих на сознание человека, сразу же вспоминают бешенство. Вирус этого заболевания обитает в слюне зараженных и, как правило, передается через укус. Попадая в организм, он поражает мозг и позвоночник, и в итоге убивает своего носителя. Но прежде у укушенных начинают появляться изменения в поведении: они становятся агрессивными, возбужденными и наглыми.
Первые признаки заболевания у людей — галлюцинации и помрачения сознания, которые зачастую сопровождаются симптомами гриппа. После распространения вируса по организму, наступает летальный исход. За все случаи клинического бешенства в США удалось спасти только десятерых пациентов.
Воспаление горла
Грипп
И снова микрофлора кишечника
Тяга или отвращение к определенным продуктам — далеко не самые страшные последствия наличия в организме этих бактерий. Сахар, который потребляет человек, питает не только его, но и микроорганизмы. К примеру, кандиды — вид дрожжей, одна из составляющих микрофлоры — растут в кишечнике и очень любят питаться сахаром. Когда этих микрогрибков становится слишком много, они начинают выделять химические вещества, вызывающие у человека желание съесть что-то сладкое.
Таким образом они способствуют росту самих себя и воздействуют на мозг носителя, вызывая у него такое же пристрастие к сахару, как и у самих бактерий.
Среди многочисленных форм глистных заболеваний следует рассмотреть лишь те формы, которые сопровождаются поражением мозга и представляют интерес для психиатрии.
а) Трихиноз. Причиной болезни являются трихины, содержащиеся в плохо сваренном либо непрожаренном мясе или колбасных изделиях. Тяжесть заболевания зависит от количества попавших в организм паразитов. Патологоанатомические исследования показали, что болезнь широко распространена в США, однако в большинстве случаев она не сопровождается явными клиническими симптомами. В Германии благодаря повсеместной борьбе с этим заболеванием оно полностью ликвидировано, хотя, правда, в военные и тяжелые послевоенные годы было отмечено несколько случаев трихиноза и даже групповые формы заболевания.
К ранним симптомам болезни, которые, однако, не всегда обнаруживаются в течение первой недели, относятся понос и боль во всем теле. Намного позднее, а именно через 2-4 недели, появляются такие симптомы, которые могут характеризовать, с одной стороны, мышечную инвазию, а с другой — аллергические явления. К ним относятся внезапно наступающие, а иногда очень интенсивные мышечные боли, температура, головные боли, отек лица. Часто наблюдается эозинофилия в крови. Любой из этих клинических симптомов бывает иногда слабо выражен или может даже совсем отсутствовать. К довольно редким явлениям относятся «оскольчатые кровоизлияния» под ногтями, кожный зуд и кожная сыпь.
Тяжелая форма заболевания сопровождается более или менее ярко выраженными нарушениями со стороны сердца и органов кровообращения. Клиническая картина болезни нередко отягощается выраженными неврологическими и психическими симптомами. В некоторых сообщениях об отдельных или массовых случаях заболевания этим явлениям не придается большого значения. Однако имеются указания на постоянную бессонницу, расширение зрачков и явления «менингизма», которые, правда, имитируются часто болями в затылочных мышцах. Среди 337 обследованных (101 летальный исход) во время большой эпидемии 1865 г., лишь у нескольких больных наблюдались делирии, большинство же отличалось крайней апатичностью и безучастностью.
Специалисты считают, что оглушенность и делириозное состояние встречаются редко и только в тяжелых случаях. Другие авторы также отрицают наличие каких бы то ни было значительных психических изменений. Но это относится к легким формам болезни, соответствующим сравнительно незначительной инвазии. Более тяжелые формы заболевания могут сопровождаться состояниями оглушения, спутанности или делириозным беспокойством. Тяжелые церебральные явления могут наблюдаться в тех случаях, когда трихины проникли в мозг и вызвали энцефалит. Именно в этих случаях у больных возникает оглушение, спутанность, делирий или сумеречное состояние.
Неврологически отмечаются симптомы раздражения или выпадения. Могут также появиться эпилептические припадки или параличи. Часты нарушения в рефлекторно-двигательной сфере. Иногда при этом возникает подозрение на полиомиелит или диссеминированный энцефаломиелит. В ликворе больного постоянно (а не только в случаях с менингеальными или церебральными симптомами) обнаруживаются личинки трихин, а признаки воспалительного процесса в ликворе могут отсутствовать.
В редких случаях психопатологические симптомы превалируют над прочими. При этом о возможности трихиноза обычно даже не предполагают. Случай, описанный Похманном, прекрасно иллюстрирует все дифференциально-диагностические трудности.
Молодая женщина 34 лет заболела остро. Больная утверждала, что не может двигаться, мочилась под себя. Состояние психомоторной заторможенности с гипомимией продолжалось около недели. Вечерами она становилась беспокойной. Через неделю психоз внезапно прекратился. Лишь тщательное изучение анамнеза привело к правильной диагностике. В этой же связи нужно упомянуть о наблюдениях Штерна.
У 35-летней женщины возник явный соматогенный психоз с явлениями спутанности, дезориентации, эпизодического беспокойства и обонятельными галлюцинациями. В больнице у больной поднялась температура, вскоре наступило помрачение сознания. Возникло подозрение на брюшной тиф. Через несколько дней больная умерла. Очень интересно, что в этом случае наблюдалось несоответствие между тяжелой клинической картиной и незначительными мозговыми изменениями. Обращает на себя внимание и тот факт, что Штерн нашел личинки трихины не в мозгу, а в диафрагме.
б) Цистицеркоз. Болезнь развивается тогда, когда яйца свиного цепня или финны попадают в верхнюю часть желудочно-кишечного тракта и развивающиеся личинки поражают организм. Через стенки капилляров паразиты проникают затем в подкожную клетчатку, мышцы, мозг, глаза, реже в легкие и печень больного, где превращаются в цистицерк. Реакция ткани на присутствие паразита начинается только тогда, когда цистицерк погибает и начинает обызвествляться.
Психопатологические явления возникают — в отличие от трихиноза — только в том случае, если личинки паразита проникли в мозг. Распространение этого заболевания в некоторых странах, например в Центральной и Южной Америке, очень велико. В Мексике из 100 больных с внутричерепными процессами 25 оказались заражены цистицерком. В Северной Америке и в большинстве европейских стран это заболевание встречается сравнительно редко. Однако в литературе описаны случаи этой болезни в Польше, Германии. Специалисты сообщают, что из 1873 больных нейрохирургического стационара это заболевание имело место у 23 человек, или в 1,22% всех случаев. Элсайсер за 12 лет в клиниках Галле наблюдал 8 случаев.
Морфологически различают несколько форм этого церебрального заболевания, которым в определенной степени соответствуют и особые клинические синдромы. К первой группе относятся случаи с отдельными или многочисленными цистами в больших полушариях, главным образом в коре. К другой группе можно отнести хронические, базальные менингиты, напоминающие туберкулезные или сифилитические. И, наконец, последняя группа включает довольно редкие случаи поражения цистицерком желудочков мозга и менингоэнцефалитическую форму. Очень редко наблюдается цистицеркоз спинного мозга.
Церебральная форма болезни обусловливает появление эпилептических припадков. Хан опубликовал данные, согласно которым судорожные припадки наблюдались в 40% случаях заболевания. Они отмечены у больных как с кортикальными цистами, так и с базальным менингитом. Иногда в этих случаях речь шла о фокальных судорожных приступах или о психомоторных припадках, в других случаях — о генерализованных припадках, при которых необходимо было исключить эпилепсию. За приступами иногда следовали сумеречные состояния. Но даже и при отсутствии припадков обнаруживаются психические расстройства того или иного характера. Иногда они сопровождаются также внезапно развившимися и часто нестойкими церебральными синдромами, характерными для сосудистых процессов. При вентрикулярном цистицеркозе могут возникнуть атипичные приступы, характерные для интермиттирующей внутренней, окклюзионной гидроцефалии. При неожиданно начавшихся интенсивных, головных болях, сопровождающихся часто сильной рвотой, может наступить состояние спутанности или ступора. В некоторых случаях очень, быстро наступает смерть.
В ходе болезни развивается прогрессирующее органическое изменение личности с более или менее тяжелой формой распада интеллекта. Подобное развитие болезнь получила, например, у одного нашего больного с многочисленными цистицерками, локализующимися прежде всего в коре мозга. У него наблюдались частые эпилептиформные припадки, затяжные сумеречные состояния.
Однако значительное изменение личности и состояние деменции могут наступить и без припадков или обратимых психозов с симптомом затемнения сознания. Тогда эти явления заставляют думать о болезни Пика или Альцгеймера или же о прогрессивном параличе.
Нужно сказать, что при базальных цистицеркозных менингитах такие психопатологические симптомы довольно часты. Неврологические расстройства, наступающие немного позднее, тоже довольно разнообразны. Сюда относятся параличи черепно-мозговых нервов, парезы конечностей, афазия, нарушения координации и гиперкинезы. Иногда речь идет о неясных нечетких очаговых симптомах. При базальных менингитах и вентрикулярном цистицеркозе раньше или позже появляется синдром повышения внутричерепного давления с головными болями, застойными сосками и, наконец, с известными из клиники отеков мозга расстройствами сознания.
Однако ни неврологические, ни психопатологические данные не могут быть решающими при установлении диагноза цистицеркоза. Во всех случаях нужно исследовать ликвор (где в пользу цистицеркоза говорит эозинофильный плеоцитоз) и провести рентгенологическое обследование (очаги обызвествления на рентгенограммах черепа, в мышцах). Следует помнить, что появление этиологически неясных соматогенных психозов — протекают ли они с явлениями затемнения сознания и потом быстро проходят или носят хронический характер — может быть обусловлено цистицеркозом. Если в ликворе обнаружен плеоцитоз и в осадке имеются эозинофилы, должно возникнуть подозрение на цистицеркоз.
в) Бильгарциоз. Болезнь принадлежит к числу наиболее распространенных тропических заболеваний и сопровождается тяжелыми осложнениями. Психические и неврологические симптомы наблюдаются редко. Еще в 1890 г. Гамагива описал случай заболевания с судорожными припадками, причиной которого были яйца глистов. Позднее неоднократно в медицинской литературе появлялись сообщения об аналогичных случаях при заболеваниях хронического характера, когда клинические явления свидетельствовали, как правило, об обширном внутричерепном процессе. В большинстве случаев речь шла о явлениях, вызванных перенесенной уже задолго до этого инфекцией с Schistosoma japonicum, реже с Schistosoma haematobium.
Отдельные наблюдения дают право сделать вывод, что непосредственно после заражения организма яйцами глистов могут также возникнуть психические и неврологические нарушения другого типа. Интересный материал был собран в 1934 г. во время группового заболевания бильгарциозом на английском военном корабле. У некоторых больных появились церебральные симптомы с явлениями затемнения сознания различной степени, делириозным беспокойством и затяжными состояниями спутанности. Наступившие параличи заставляли думать об эпидемическом энцефалите.
Вторая мировая война значительно расширила наши познания о клинике этого заболевания. Областью распространения Schistosoma japonicum являются некоторые районы Японии и Китая, острова Формоза, Целебес и Филиппины. В 1944 г. среди расквартированных на Филиппинах американских солдат были обнаружены случаи заболевания шистосоматозом. По данным специалистов, за короткий период с октября 1944 г. по март 1945 г. было зафиксировано 1500 таких случаев. Клинические явления, и прежде всего неврологическая и психиатрическая симптоматология этих случаев, описаны в многочисленных отдельных работах и обзорах. Как утверждает Мост и его сотрудники, в 2,5% случаев обнаруживаются симптомы со стороны нервной системы. После острой стадии заболевания, сопровождающейся температурой, головными болями, отсутствием аппетита, кашлем, мышечными болями и крапивницей, возникают явления, свойственные энцефалиту. Некоторые больные находились в состоянии сонливости, другие были беспокойны, дезориентированы и обнаруживали явления спутанности.
Карролл сообщает о молодом офицере, который почти все время был сонливым и апатичным, но иногда вдруг начинал громко петь или же что-то шептать. В 4 из 15 случаев, с признаками раннего поражения центральной нервной системы наблюдалось резкое беспокойство, иногда маниакальное. Такие психотические расстройства нередко длятся в течение нескольких недель. Одновременно с этим развиваются различные неврологические нарушения, чаще всего параличи конечностей с пирамидными знаками (часто двусторонние). Наблюдаются нарушения чувствительности, координации и расстройства речи, однако в этих случаях эпилептические припадки не отмечались. Неврологические расстройства исчезали через несколько недель или даже месяцев.
У другой группы больных обычные симптомы инфекционного заболевания вначале отсутствовали, но через значительный отрезок времени (несколько месяцев, а иногда и лет), в течение которого у больного не наблюдалось никаких болезненных явлений, неожиданно появлялись церебральные симптомы, указывающие в большинстве случаев на обширный внутричерепной процесс. Сюда относятся судорожные припадки, застойный сосок, центральные параличи, расстройства движений и чувствительности. Психопатологические картины этой поздней стадии заболевания характеризуются, с одной стороны, эпилептиформными синдромами, а с другой — обратимыми и необратимыми синдромами, наблюдающимися при отеках мозга.
Человек считает себя вершиной эволюции. Однако так ли это? Ведь есть существа более приспособленные для жизни на планете и намного дольше обитающие на ней.

БАКТЕРИАЛЬНЫЕ ПСИХОЗЫ.
Журнал New Scientist рассказал о подростке – Сэмми Малони. В 12 лет Сэм начал обнаруживать признаки психического расстройства. Медики ставили различные психиатрические диагнозы перед тем как обнаружили причину недуга. Ей оказалась бактерия стрептококк. Из-за того что мальчик наряду со странными проявлениями психики очень сильно чесался его направили на анализ целью которого было выявить инфекцию вызывающую зуд. После лечения антибиотиками мальчик стал здоров. Стрептококовых бактерий много, как и болезней ими вызываемых. Это в том числе и обычная ангина. Ученые предполагают, что у одного из тысячи человек, перенесших это заболевание, развивается невроз навязчивых состояний в результате того, что стрептокок вызывает чрезмерную реакцию иммунной системы и поражает определенные клетки головного мозга.
Мадлен Каннингем из Университета Оклахомы сообщает что бактерии способны проникать в мозг человека. В зону, контролирующую моторные реакции. Там стрептококки своей жизнедеятельностью стимулируют выброс нейространсмиттера допамина. Это имитирует работу естественных сигнальных молекул и является ложными командами для организма человека вызывающими нервный тик, провоцирующими эмоциональные всплески, когнитивные расстройства, иногда деже вспышки агрессии
ОТ ГЕРПЕСА ГЛУПЕЮТ. ГЕРПЕСНАЯ ШИЗОФРЕНИЯ.
Так считает Стивен Бука из Гарвардского университета в Бостоне. Он обнаружил, что люди, зараженные вирусами генитального герпеса обнаруживают такой феномен и сильно рискуют стать с годами шизофрениками или приобрести другие психозы, что показала статистика. Объяснить как именно герпес воздействует на мозг человека ученый пока не может.
В качестве эксперимента ученый проследил судьбу младенцев родившихся в 1959 – 1966-х годах, город Провиденс. Все они были заражены генитальным герпесом от матерей. 27 из них попали в психушку. Возбудителей других венерических болезней у них не было. Хотя Бука грешил еще и на хламидии, и на трихомонады. Похоже на психику воздействовал только герпес. Его вирусы приводили к психическим расстройствам за 25 – 30 лет пребывания в организме. Так же причиной шизофрении могут стать цитомегаловирус, вирус Эпштейн-Бара и, возможно, вирус краснухи, полиомиелит, корь, ветряная оспа, мононуклеоз.
ГРИБКИ ВЫЗЫВАЮТ ГАЛЛЮЦИНАЦИИ
Влияние плесени на мозг объясняет встречи людей с потусторонними сущностями и призраками. К такому заключению пришли исследователи из США. Сложился некий стереотип о том, что призраки живут в старых или заброшенных домах. Причиной таких встреч с призраками ученые назвали воздействие на мозг некоторых плесневых грибов. Такое исследование проводят ученые Университета Кларксона, штат Нью-Йорк. Так же токсично влияют на мозг химические выделения термитов.
СПИРОХЕТЫ СИФИЛИСА РАЗРУШАЮТ МОЗГ.
Бактерия Treponema pallidum вызывает сифилис. Это хроническое системное венерическое инфекционное заболевание (передающиеся половым путем). Характеризуется поражением кожи, слизистых оболочек, внутренних органов, костей, нервной системы. Симптомы сифилиса зависят от стадии протекания болезни и иммунитета больного. Разновидностей протекания болезни огромное множество в том числе есть и скрытые вариации протекания болезни. Бледная спирохета проникая в организм человека поражает центральную нервную систему, сосуды головного мозга, а затем и все ткани организма. Третичный сифилис это та стадия на которой можно наблюдать сильное влияние на психику человека. Больной может впадать в депрессии с галюцинациями, могут отмечаться проявления ярости, параноидальные видения, деменция, эйфория и шокирующая наивность вызванные слабоумием.
АПАТИЯ МОЖЕТ БЫТЬ ВЫЗВАНА БРУЦЕЛЛЁЗОМ.

ТОКСОПЛАЗМОЗ, ЗАТОРМОЖЕННОСТЬ И ГЛУПАЯ СМЕЛОСТЬ
Toxoplasma gondii -это паразит, который вызывает психотические приступы. Исследования показывают, что это мельчайшее существо не плохо приспособилось в большом и сложном мире. Оно вырабатывает химические вещества похожие на LSD. В университете Чарльз в Праге работали над статистикой ДТП и выявили что она связана с Toxoplasma gondii. Это объясняется тем, что реакция больного слегка замедленна, что может привести к риску ДТП. Так же у больных может наблюдаться болезненная самонадеянность и смелость. Дело в том, что таксоплазмоз затрагивает людей лишь попутно. Его основные обитатели это коты и мыши. Мышь больная таксоплазмозом находит запах кошачей мочи удивительно привлекательным и сама идет на хищника, который недоумевает, но съедает мышь вместе с таксоплазмой. Так происходит заражение пушистого борца с грызунами. После чего с мочой и калом таксоплазма попадает во внешнюю среду и заражает прежде всего мышей, но иногда и человека тоже. Человек хоть и в значительно более слабой степени, но приобретает странные черты поведения являющиеся результатом влияния таксоплазмы. Этот вирус несет опасность для плода при беременности. Перед запланированной беременностью обычно обязательно проверяются на таксоплазмоз и производят лечение в случае необходимости.
БОЛЕЗНЬ ЛАЙМА ПРИЧИНА ДЕПРЕССИИ
Давно известно о том, что некоторые заболевания вызывают расстройства психики. С появлением пенициллина тысячи человек смогли избавиться от ряда психических расстройств. Современные ученые обнаружили, что инфекции играют значительную роль в психическом здоровье человека. Даже такие болезни, как навязчивые состояния, раздвоение личности и шизофрения могут быть связаны с деятельностью различных паразитов, вирусов, бактерий в организме.
В настоящие время устанавливается связь инфекционных заболеваний с синдромом Туретта.
БЕШЕНСТВО ВИРУСНОЕ ЗАБОЛЕВАНИЕ
ГЕЛЬМИНТОЗНАЯ ТРЕВОЖНОСТЬ И ПАРАНОЙЯ.
Болезнь вызываемая паразитическими червями. Паразиты питаются ценными элементами, такими как витамины группы В, необходимыми для полноценной деятельности нервной системы. В результате чего происходит голодание нервных клеток и человек становится раздражительным, злым, у него появляются параноидальные мысли, меняется поведение.
БАКТЕРИАЛЬНЫЕ ЯЗВЫ ЖЕЛУДКА.
ИНФАРКТ И ИНСУЛЬТ ВЫЗЫВАЮТ ХЛОМИДИИ.
Сердечно-сосудистые заболевания. Какова причина? Холестерин от которого на стенках сосудов появляются бляшки препятствующие поступлению крови к сердцу? Принято считать, что когда бляшки разрушаются и отрываются появляются сгустки в крови. Эти сгустки слипаются и закупоривают сосуды. Если они заблокируют сосуды питающие сердце случится инфаркт. А если сосуд головного мозга – инсульт.
Только вот в чем загвоздка: половина людей столкнувшихся с этой болезнью имеют нормальный уровень холестерина. Дэвид Грейнджер из Кембриджского университета уверяет что во многих случаях избыток холестерина ни при чём. В крови и в бляшках больных обнаружили хломидии. Они вызывают воспаление стенок сосудов и тканей сердца в результате чего их поверхность становится липкой. К липкой субстанции прилипают иммунные клетки, которые вместе с мышечными клетками извлекают из крови холестерин. Создается пробка, полная жира. Выходит причина инфарктов и инсультов бактериальная или венерическая. Хломидиоз передается в основном половым путем.
БАКТЕРИАЛЬНОЕ ОЖИРЕНИЕ.
Доктор Лея Уигхем из университета Висконсина (США) обращает внимание на то что ожирение распространяется словно эпидемия.
Ученая уверяет, что это передается от человека к человеку аденовирусами ( возбудителями простуды). Они заставляют жировые клетки активнее расти и делиться, но ученые не могут понять зачем. Возможно это побочный эффект деятельности вируса. Аденовирусами заражены 20% американцев и исследования показали что, как правило, это люди с лишним весом.
10% от всех болезней составляют психиатрические заболевания и этот процент растет. Фуллер Торри, психиатр из Медицинского научно-исследовательского института в Мериленде, заметил, что наблюдаются некоторые пики, когда количество заболеваний превышало норму, что походит на эпидемические вспышки.
Не забывайте, что кроме химических антибиотиков, которые следует использовать очень аккуратно и правильно дабы не допустить мутации микроорганизмов в результате чего они станут устойчивыми к антибиотикам и еще более опасными, есть так же природные консерванты и антибиотики. Это специи: куркума, корица. Некоторые травы такие как календула, ромашка. Соль, уксус, кипячение, солнечные лучи. Берегите себя и своё здоровье. Если вы можете дополнить статью информацией о заболеваниях и психологических состояниях связанных с бактериями, вирусами или грибками напиши те об этом в комментариях.
Читайте также:






















